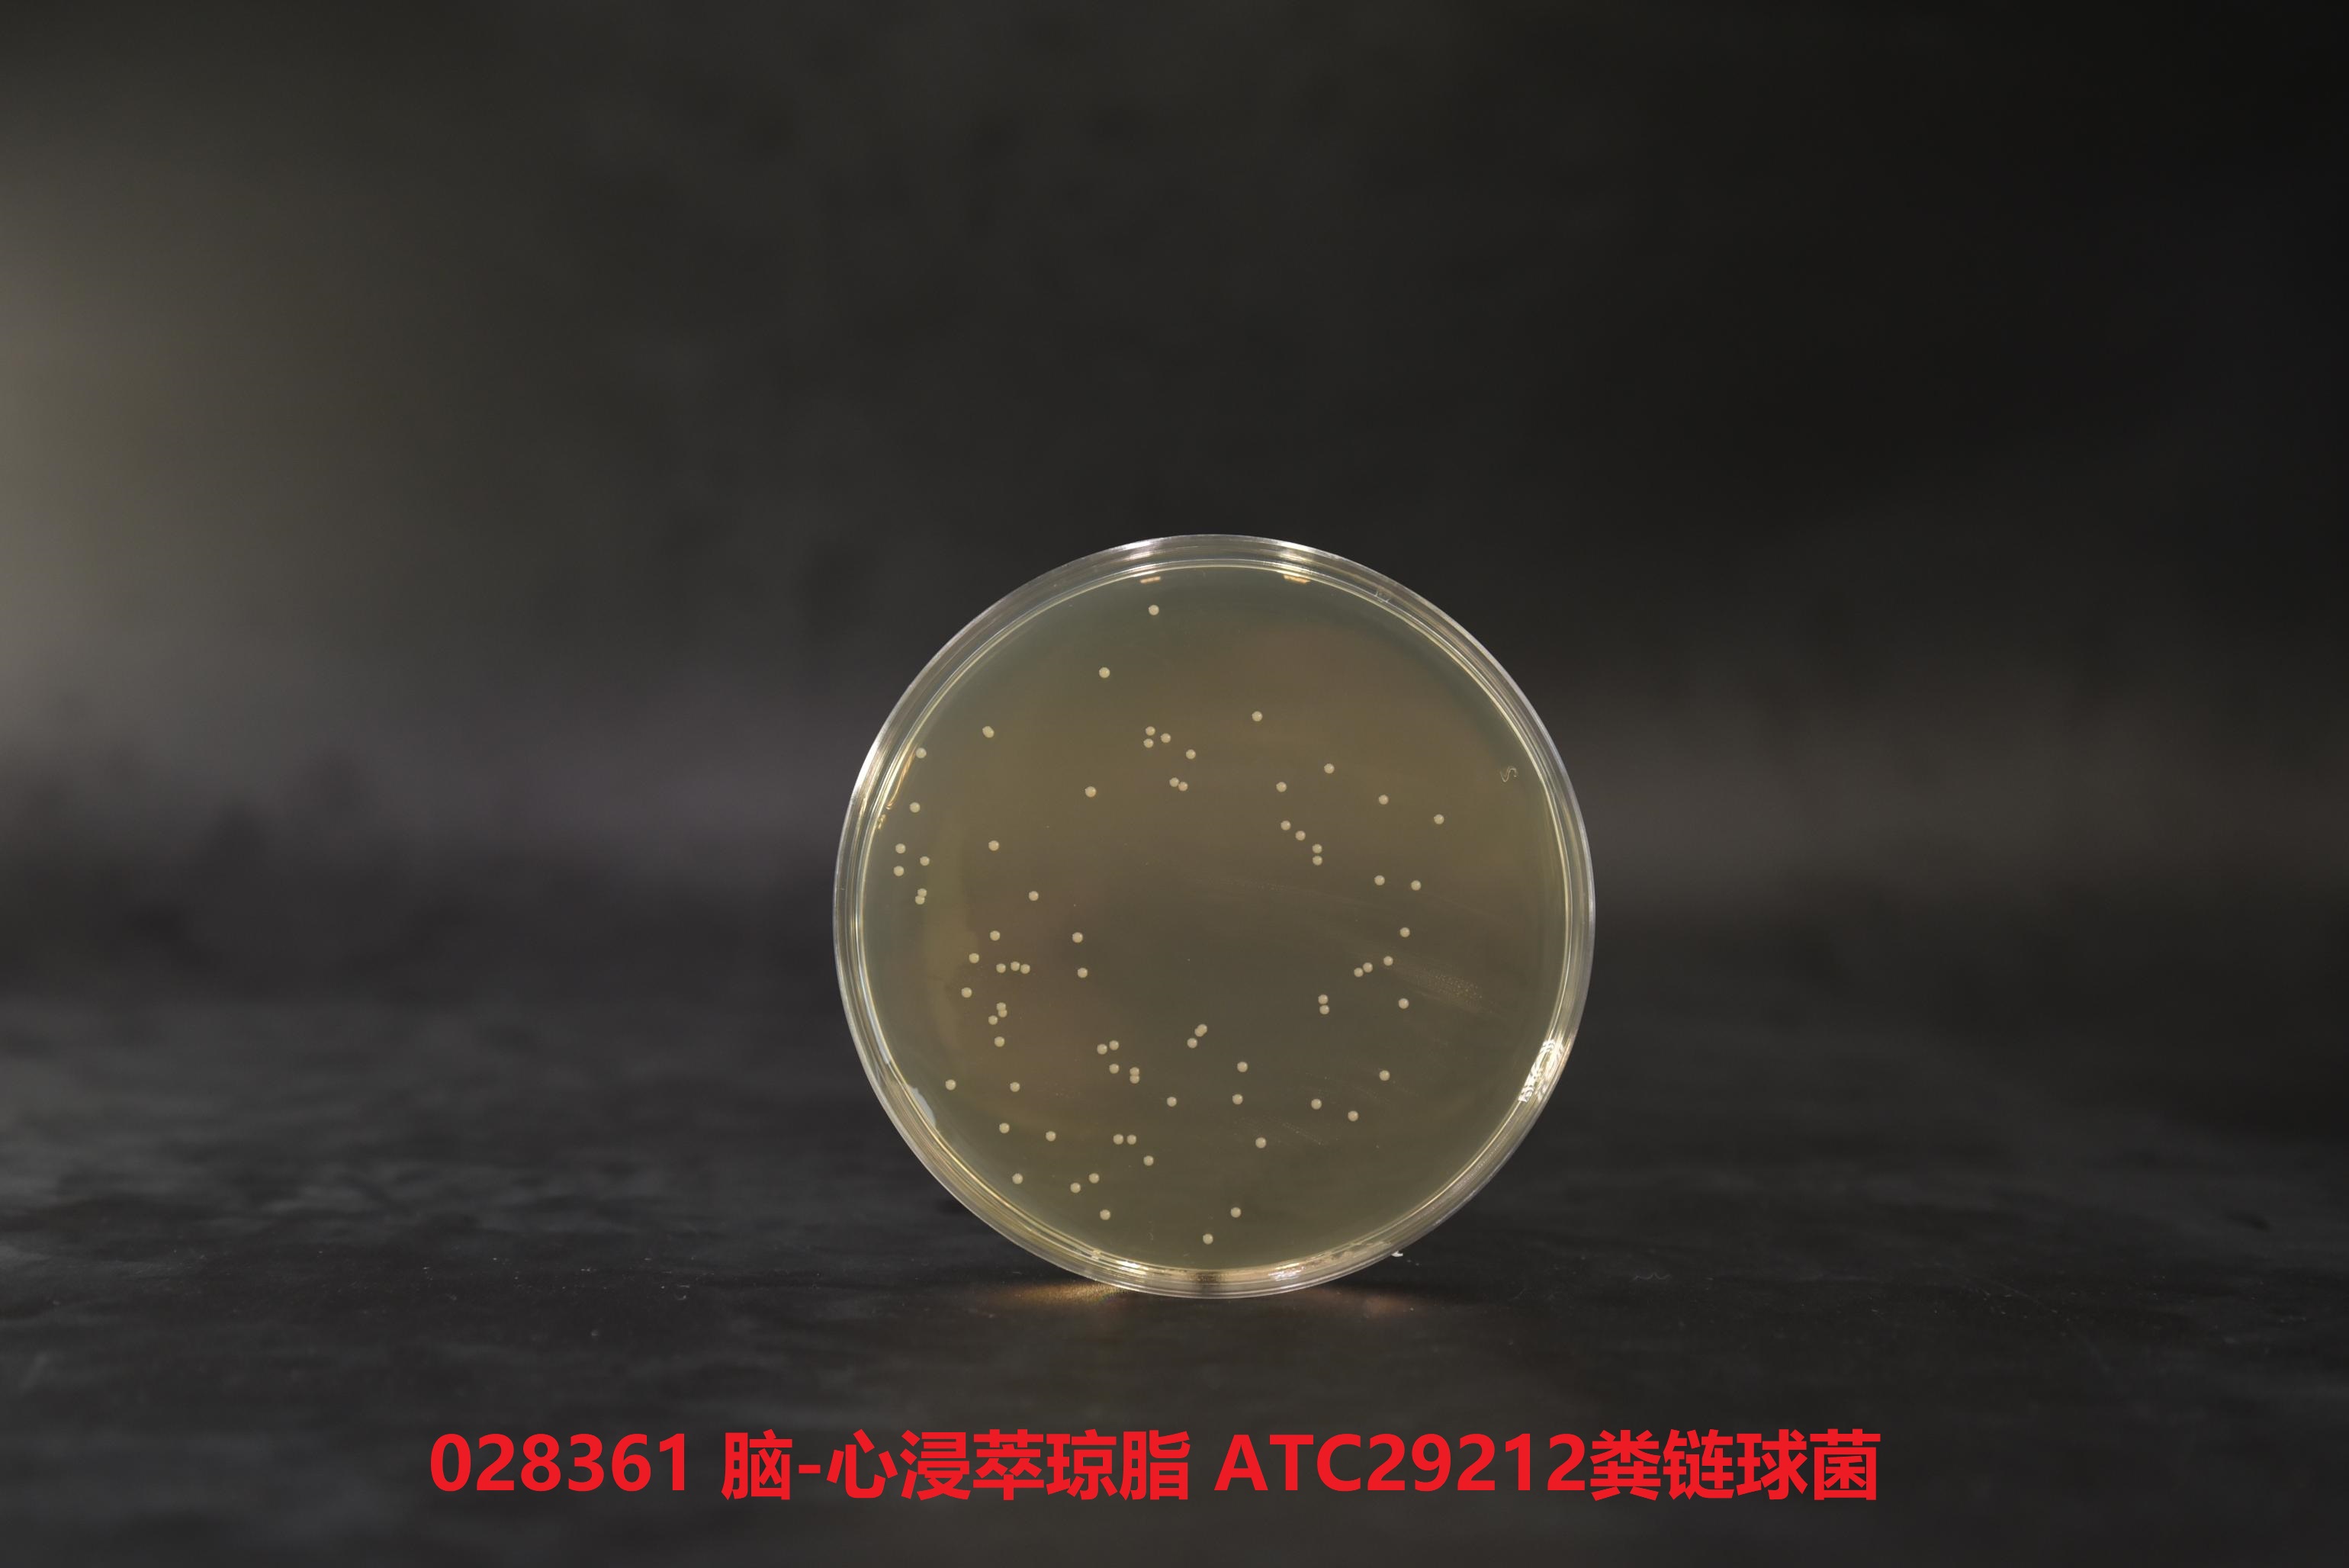
糞腸球菌ATCC29212 糞腸球菌ATCC29212

注:
本產品可用公司研發(fā)生產的 028363 腦心浸液瓊脂培養(yǎng)基(GB8538-2022) 干粉 100g 進行替代, 腦心浸液瓊脂培養(yǎng)基(GB8538-2022) 的產品鏈接地址:https://www.huankai.com/show/43362.html。
環(huán)凱 028363 腦心浸液瓊脂培養(yǎng)基 可用于礦泉水和城市供水中糞性鏈球菌濾膜法的確證性實驗!
產品名稱:腦心浸液瓊脂(腦-心浸萃瓊脂培養(yǎng)基)
英文名稱:Brain Heart Infusion Agar
其它叫法:BHIA培養(yǎng)基
產品編號與包裝規(guī)格:
| 產品編號 | 產品類型 | 包裝規(guī)格 |
| 028361 | 干粉 | 100g/瓶 |
產品用途:廣泛用于霉菌、酵母、細菌的培養(yǎng),包括營養(yǎng)要求較高的微生物的培養(yǎng),特別用于礦泉水和城市供水中糞性鏈球菌濾膜法的確證性實驗。
腦心浸液瓊脂檢驗原理:月示胨和腦—心浸粉提供氮源、維生素和生長因子;葡萄糖可為多種細菌提供能源;氯化鈉維持均衡的滲透壓;磷酸氫二鈉為緩沖劑。
配方成分:
| 配方(每升) | 含量 |
| 幼牛腦(提取浸出粉) | 200.0g |
| 牛心(提取浸出粉) | 250.0g |
| 葡萄糖 | 2.0g |
| 氯化鈉 | 5.0g |
| 月示胨 | 10.0g |
| 磷酸氫二鈉 | 2.5g |
| 瓊脂 | 15.0g |
| 最終pH 7.4±0.2 | |
使用方法:稱取本品52g,加入蒸餾水或去離子水1 L,攪拌加熱煮沸至完全溶解,分裝或者三角瓶,121℃滅菌15min。
質量控制:下列質控菌株接種后于35~37℃培養(yǎng)18-24h,觀察結果如下表:
| 指標 | 質控菌株及編號 | 標準值 | 特征性反應 |
| 生長率 | 糞腸球菌ATCC29212 | PR≥0.9 | 灰白色菌落 |
| 乙型溶血性鏈球菌ATCC21059 | 灰白色菌落 | ||
| 大腸埃希氏菌ATCC25922 | 灰白色菌落 |

參考文獻:
CJ/T141-2018中華人民共和國城鎮(zhèn)建設行業(yè)標準 城市供水水質檢驗
GB 8538-2016 中華人民共和國國家標準 飲用天然礦泉水檢驗方法
SN/T2206.4-2009 中華人民共和國出入境檢驗檢疫行業(yè)標準 化妝品微生物檢驗方法 第5部分:鏈球菌
腦心浸液瓊脂(腦-心浸萃瓊脂培養(yǎng)基) 相關產品(用于細菌總數測定及增菌培養(yǎng)):
| 產品名稱 | 產品貨號 | 規(guī)格 | 產品說明及用途 |
| SCDLP液體培養(yǎng)基 Soya Casein Digest Lecithin Polysorbate Broth | 027010 | 250g | 用于疏水性化妝品樣品處理及化妝品和一次性使用衛(wèi)生用品中細菌的增菌培養(yǎng)(GB、ISO) |
| 改良卵磷脂肉湯 Modified Letheen Broth | 027012 | 250g | 用于化妝品微生物檢驗中樣品稀釋和增菌(美國FDA、ISO) |
| 改良卵磷脂瓊脂 Modified Letheen Agar | 027023 | 250g | 用于化妝品微生物檢驗中樣品稀釋和增菌(美國FDA、 ISO) |
| 卵磷脂-吐溫80營養(yǎng)瓊脂 (TTC卵磷脂-吐溫80營養(yǎng)瓊脂基礎) Lecithin Tween-80 Nutrient Agar(TTC Lecithin Tween-80 Nutrient Agar Base) | 027020 | 250g | 用于化妝品細菌總數測定,臨用前可加入TTC,制成TTC卵磷脂-吐溫80營養(yǎng)瓊脂,使菌落成紅色(GB, 化妝品衛(wèi)生規(guī)范2015) |
| LB肉湯(含糖) LB Broth(with sugar) | 028320 | 250g | 用于一般細菌培養(yǎng),特別用于分子生物學試驗中大腸桿菌的保存和增菌 |
| LB肉湯(不含糖) LB Broth(no sugar) | 028324 | 250g | 用于分子生物學中大腸桿菌的培養(yǎng)(美國FDA,lennox) |
| LB瓊脂(不含糖) LB Agar(no sugar) | 028334 | 250g | 用于分子生物學中大腸桿菌的培養(yǎng)(美國FDA,lennox) |
| 氨芐青霉素LB瓊脂 LB Agar with Ampicillin | 028335 | 250g | 用于分離含有抗氨芐青霉素質粒的大腸桿菌 |
| pH7.0氯化鈉-蛋白胨緩沖液 Buffer Sodium Chloride | 022116 | 500g | 用于藥品、生物制品的樣品稀釋(2020版CP、USP、EP) |
| 胰酪大豆胨液體培養(yǎng)基(TSB) Tryptic Soy Broth | 024048 | 250g | 用于藥品及生物制品的無菌檢查以及需氧菌MPN法計數(2020版CP、USP、EP) |
| 胰酪大豆胨液體培養(yǎng)基(TSB) Trypticase Soy Broth | 024048T1 | 10kg | 用于藥品及生物制品的無菌檢查以及需氧菌MPN法計數(2020版CP、USP、EP) |
| 硫乙醇酸鹽流體培養(yǎng)基(FT)(藥典) Fluid Thioglycollate Medium | 028033 | 250g | 用于培養(yǎng)需氧菌、微需氧菌和厭氧菌,還用于藥品生物制品的無菌試驗(2020版CP、USP、EP) |
| 硫乙醇酸鹽流體培養(yǎng)基(高透明度) Thioglycollate Medium(Excellent Clarity) | 028034 | 250g | 用于培養(yǎng)需氧菌、微需氧菌和厭氧菌,還用于藥品生物制品的無菌試驗(2020版CP、USP、EP) |
| 胰酪大豆胨瓊脂培養(yǎng)基 (大豆酪蛋白瓊脂培養(yǎng)基)(TSA) Soybean Casein Digest Agar (Tryptic Soy Agar) | 028074 | 250g | 用于一般細菌培養(yǎng),需氧菌總數計數及環(huán)境監(jiān)測(2020版CP、USP、EP、GB) |
| R2A瓊脂培養(yǎng)基 R2A Agar | 022029 | 250g | 用于水中細菌總數的測定(2020版CP、 USP、EP) |
| 0.5%葡萄糖肉湯培養(yǎng)基 0.5% Dextrose Broth | 028032 | 250g | 用于硫酸鏈霉素等抗生素的無菌檢查及消毒技術規(guī)范(GB) |
| 平板計數瓊脂(含糖瓊脂PCA) Plate Counts Agar | 022070 | 250g | 用于細菌總數的測定(GB、SN、美國FDA、ISO) |
| 營養(yǎng)瓊脂(NA)培養(yǎng)基(藥典) Nutrient Agar Ⅱ | 022021 | 250g | 供細菌總數測定、保存菌種及純培養(yǎng)用(CP) |
| 營養(yǎng)肉湯培養(yǎng)基(藥典) Nutrient Broth Ⅱ | 022011 | 250g | 用于一般細菌培養(yǎng)、轉種、復壯、增菌等(CP) |
| 0.1%蛋白胨水 0.1% Peptone Water | 028026 | 250g | 用于樣品的稀釋(CP) |
| 磷酸鹽緩沖液(PBS) Peptone Buffered Solution | 022117 | 250g | 用于樣品的稀釋(CP) |
| 蛋白胨-鹽溶液 Peptone Salt Solution | 027405 | 250g | 用于乳與乳制品中嗜冷菌測定樣品的稀釋(NY/T1331-2007) |
| 營養(yǎng)肉湯(NB)培養(yǎng)基 Nutrient Broth | 022010 | 250g | 一般細菌培養(yǎng)、轉種、復壯、增菌等,也可用于消毒效果測定(GB) |
| 營養(yǎng)瓊脂(NA)培養(yǎng)基 Nutrient Agar | 022020 | 10kg | 供細菌總數測定、保存菌種及純培養(yǎng)用,也可用于消毒效果測定(GB、 ISO) |
| LG培養(yǎng)基 LG Medium | 021140B | 10kg | 用于霉菌、酵母菌、耐熱霉菌及細菌總數的檢測,可用于 PET瓶及無菌罐裝生產線的無菌測試 |
| M-TGE肉湯 mTGE Broth | 022075 | 250g | 用于濾膜法細菌總數計數 |
| 橙血清瓊脂 Orange Serum Agar | 027400 | 250g | 用于培養(yǎng)耐酸的微生物,特別是柑橘產品的微生物 |
| 液體硫乙醇酸鹽培養(yǎng)基(FT) Fluid Thioglycollate Medium | 028030 | 250g | 用于培養(yǎng)需氧菌、微需氧菌和厭氧菌,及食品中產氣莢膜梭菌的厭氧培養(yǎng)(美國FDA、GB、SN) |
| 胰蛋白胨大豆肉湯(TSB) Trypticase(Tryptic) Soy Broth (Soybean Casein Digest Broth) | 024051 | 250g | 用于廣泛微生物培養(yǎng),尤其是金黃色葡萄球菌、溶血性鏈球菌、蠟樣芽孢桿菌檢驗(GB、美國FDA) |
| 腦心浸出液肉湯(BHI) Brain Heart Infusion Broth | 024053 | 250g | 用于金黃色葡萄球菌的培養(yǎng),還可用于霉菌、酵母、細菌的培養(yǎng),包括營養(yǎng)要求較高的微生物的培養(yǎng)(GB、 美國FDA、ISO) |
| 溴甲酚紫葡萄糖蛋白胨水培養(yǎng)基 BCP Dextrose Peptone Medium | 028073 | 250g | 用于壓力蒸汽滅菌效果評價(GB) |
| 酸性肉湯 Acid Broth | 027110 | 250g | 用于酸性罐頭食品商業(yè)無菌檢驗(GB、美國FDA) |
| 溴甲酚紫葡萄糖肉湯 Bromcresol Purple Dextrose Broth | 027100 | 250g | 用于培養(yǎng)細菌和鑒別細菌發(fā)酵葡萄糖試驗,還用于低酸性罐頭食品商業(yè)無菌檢驗(GB、美國FDA) |
| TTC營養(yǎng)瓊脂 TTC Nutrient Agar | 022030 | 250g | 供測定細菌總數用,本品能防止菌落蔓延,使菌落變紅易計數 |
| 哥倫比亞瓊脂培養(yǎng)基 Columbia Agar | 024061 | 250g | 加或不加脫纖維羊血或免血,用于營養(yǎng)要求較高的細菌培養(yǎng)及溶血試驗,或用于梭菌檢驗(GB) |
| 錳鹽營養(yǎng)瓊脂 Manganese Nutrient Agar | 027120 | 250g | 用于嗜溫或嗜熱的需氧或厭氧芽孢桿菌的檢測和培養(yǎng)(GB) |
